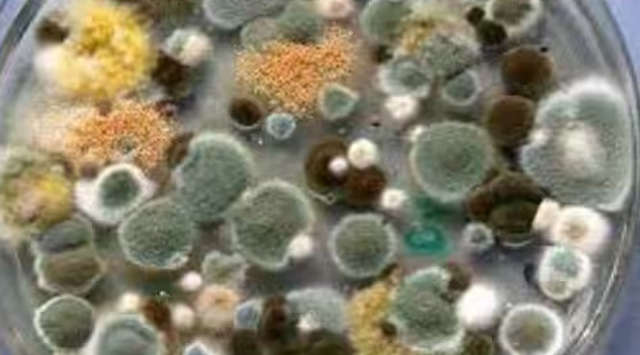

കാലാവസ്ഥാ വ്യതിയാനവും താപനിലയിലെ വർദ്ധനവും ആസ്പർജില്ലസിന്റെ വ്യാപനത്തിന് കാരണമാകുന്നുവെന്ന് അടുത്തിടെ നടത്തിയ ഒരു പഠനം വെളിപ്പെടുത്തി . മനുഷ്യന്റെ ആരോഗ്യത്തിനും ഭക്ഷ്യ സുരക്ഷയ്ക്കും ഒരുപോലെ അപകടമുണ്ടാക്കുന്ന മാരകമായ അണുബാധയാണ് ആസ്പർജില്ലസ് .
ആഗോള താപനിലയിലെ വർദ്ധനവ് ആസ്പർജില്ലസ് ഫംഗസിന് കാരണമായേക്കാം. ഇത് നിരവധി മരണങ്ങൾക്ക് കാരണമാകുമെന്ന് പുതിയ ഗവേഷണം വെളിപ്പെടുത്തുന്നു. മാഞ്ചസ്റ്റർ സർവകലാശാലയിലെ ശാസ്ത്രജ്ഞർ വിശദീകരിക്കുന്നതുപോലെ, പലതരം ആസ്പർജില്ലസ് ലോകത്ത് വ്യാപിക്കുകയും ആളുകളെയും വളർത്തുമൃഗങ്ങളെയും സസ്യങ്ങളെയും ബാധിക്കുകയും ചെയ്യും. ദി ലാൻസെറ്റും സിഎൻഎന്നും പറയുന്നതനുസരിച്ച്, ഈ പഠനം നിലവിൽ ഒരു കൂട്ടം അന്താരാഷ്ട്ര വിദഗ്ധർ അവലോകനം ചെയ്യുകയാണ്.
ആസ്പർജില്ലസ് എന്താണ്?
ലോകത്തിന്റെ പല ഭാഗങ്ങളിലും, ആസ്പർജില്ലസിനെ ഒരു സാധാരണ ഫംഗസ് ഗ്രൂപ്പായി അംഗീകരിച്ചിട്ടുണ്ട്. ഇത് മാരകമായ ആസ്പർജില്ലോസിസ് ഉണ്ടാക്കുന്നു. പ്രധാനമായും ശ്വാസകോശത്തെയാണ് ബാധിക്കുന്നത്. ഭാവിയിൽ ആസ്പർജില്ലസ് എവിടെ പടരുമെന്ന് ട്രാക്ക് ചെയ്യാൻ ഗവേഷകർ നിരവധി തരം മോഡലിംഗ്, പ്രവചന സാങ്കേതിക വിദ്യകൾ ഉപയോഗിക്കുകയാണ്. കാലാവസ്ഥാ പ്രതിസന്ധി രൂക്ഷമാകുമ്പോൾ ഭാവിയിൽ വികസിക്കുന്ന പ്രത്യേക ആസ്പർജില്ലസ് സ്പീഷീസുകൾ ഉണ്ടെന്ന് ഗവേഷണത്തിന്റെ ഭാഗമായി ശാസ്ത്രജ്ഞർ കണ്ടെത്തി.
കാനഡ, യുഎസ്, യൂറോപ്പ്, ചൈന, റഷ്യ എന്നീ രാജ്യങ്ങളിലേയ്ക്ക് ഈ ജീവിവർഗ്ഗങ്ങൾ വ്യാപിക്കും. പഠനത്തിന്റെ രചയിതാക്കളിൽ ഒരാളായ നോർമൻ വാൻ റിജൻ പറയുന്നത് ലോകത്തിലെ പ്രധാന മേഖലകളെ ഇവ ബാധിക്കുമെന്നാണ്.
ഈ അണുബാധ ഇത്ര മാരകമായിരിക്കുന്നത് എന്തുകൊണ്ട്, ആർക്കാണ് അപകടസാധ്യത?
എല്ലാ വർഷവും ഫംഗസ് അണുബാധകൾ 2.5 ദശലക്ഷത്തിലധികം ആളുകളുടെ ജീവൻ അപഹരിക്കുന്നുവെന്ന് കണക്കാക്കപ്പെടുന്നു. എല്ലാ ഡാറ്റയും ലഭ്യമല്ലാത്തതിനാൽ ഈ സംഖ്യ ഇതിലും കൂടുതലാകാൻ സാധ്യതയുണ്ട്. പല ഫംഗസുകളെയും പോലെ, ആസ്പർജില്ലസ് മണ്ണിൽ ചെറിയ ഫിലമെന്റസ് ഘടനകളായി പ്രത്യക്ഷപ്പെടുന്നു. തുടർന്ന്, അവ വായുവിലൂടെ സഞ്ചരിക്കുന്ന നിരവധി ബീജങ്ങളെ സൃഷ്ടിക്കുന്നു. എല്ലാ ദിവസവും, മനുഷ്യർ ഈ വായു മലിനീകരണം ആഗിരണം ചെയ്യുന്നു.
സാധാരണയായി, മിക്ക ആളുകളുടെയും ആരോഗ്യത്തിന് ഒരു കുഴപ്പവും ഉണ്ടാകാറില്ല, കാരണം അവരുടെ രോഗപ്രതിരോധ സംവിധാനത്തിന് ഇത്തരം ഭീഷണികളെ നേരിടാൻ കഴിയും. ആസ്ത്മ, സിസ്റ്റിക് ഫൈബ്രോസിസ് അല്ലെങ്കിൽ സിഒപിഡി എന്നിവയാൽ ബുദ്ധിമുട്ടുന്ന വ്യക്തികൾക്ക് ഇങ്ങയൊവണമെന്നില്ല. കാൻസർ അല്ലെങ്കിൽ അവയവം മാറ്റിവയ്ക്കൽ ശസ്ത്രക്രിയ നടത്തിയ രോഗികൾക്ക് രോഗപ്രതിരോധ ശേഷി ദുർബലമാകുന്നതിനാൽ അപകടസാധ്യത കൂടുതലാണ്. വാൻ റിജിന്റെ അഭിപ്രായത്തിൽ, നിങ്ങളുടെ രോഗപ്രതിരോധ സംവിധാനത്തിന് ഫംഗസിനെ തടയാനായില്ലെങ്കില് ഫംഗസ് വളരാൻ തുടങ്ങും. തുടര്ന്ന് നിങ്ങളെ അത് ഉള്ളിൽ നിന്ന് കീഴടക്കുകയും ചെയ്യും. – വാൻ റിജൻ പറഞ്ഞു.
ഉഷ്ണമേഖലാ പ്രദേശങ്ങളിലാണ് ഇവ പെട്ടെന്ന് വളരുന്നത്. ഫോസിൽ ഇന്ധനങ്ങളെ ആശ്രയിക്കുന്നത് തുടർന്നാൽ ആസ്പർജില്ലസ് ഫ്ലാവസ് വ്യാപ്തി 16% വർദ്ധിക്കുമെന്ന് പഠനം പറയുന്നു. കാൻഡിഡ സ്പീഷീസുകൾ വളരെ ഗുരുതരമായ അണുബാധകൾക്ക് കാരണമാകുകയും ചില മരുന്നുകളോട് ഇപ്പോഴും പ്രതിരോധശേഷിയുള്ളവയുമാണ്. ഇക്കാരണത്താൽ, അണുബാധ വിവിധ ഭക്ഷ്യവിളകളിലേക്ക് വ്യാപിക്കുകയും ഭക്ഷ്യസുരക്ഷയ്ക്ക് ഗുരുതരമായ പ്രശ്നമായി മാറുകയും ചെയ്യും.